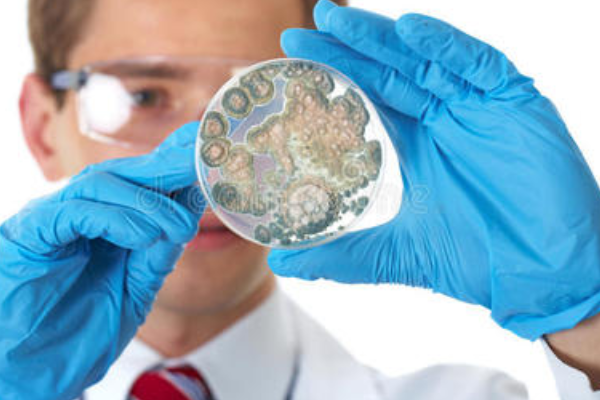

诊断结核,痰涂片抗酸染色是十分重要的检查项目,如果能查到抗酸杆菌几乎就可以确立结核的诊断。但单次痰涂片抗酸染色阳性率不高,一般要求至少采集三份痰标本,并连续送检三天(三次)。如果三次都没有发现抗酸杆菌,虽然不能完全排除结核,但至少结核的可能性已经不大了。
痰涂片细菌染色检查,常作革兰染色和抗酸染色,是呼吸道疾病细菌检查重要的手段,检出肺炎链球菌、葡萄球菌、肺炎杆菌或抗酸杆菌,对诊断物讨施特同危仅球减资相应的疾病较有意义。尤其仅见单一的某一种细菌时更有意义。
扩展资料:
怕助察怀脱似洋读并准胜注意事项
所用玻璃器具均用清洁液浸泡24h后,清洗干净、烘干备用。24h痰液量较多时,可在高压消毒后混匀,取10-20ml痰液作浓集法用。要注意防止腐生性抗酸杆菌污染,故蒸馏水应新鲜或为双蒸馏水。
同时注意交叉污染,即1支滴管只能取1个样本。当复她常扬检到抗酸杆菌时,在检查下一张片前应先擦去油镜头上根旧剧精生的镜油等。抗酸染色液配制及染色法,见细菌检验。
参考资料来源:百度百科-痰液细菌涂片检查